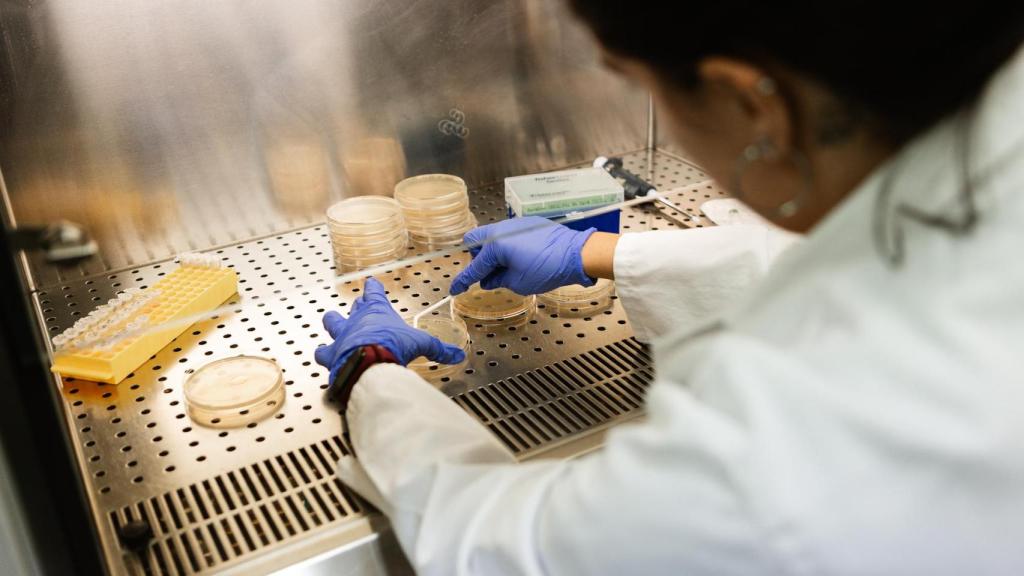
Investigación en la ULE

Investigación en la ULE
Sobresaliente para una universidad de Castilla y León por su actividad investigadora
La Agencia de Evaluación de la Calidad y la Acreditación (ANECA) valida de forma positiva las 60 solicitudes de sexenios presentadas por el personal investigador funcionario de la Universidad de León.
Más información: Un innovador botellín diseñado en León que mantiene los líquidos a 10 grados por debajo de la temperatura ambiente
Noticias relacionadas
La Universidad de León (ULE) ha conseguido un resultado sobresaliente en la convocatoria 2024 de evaluación de la actividad investigadora de la Agencia Nacional de Evaluación de la Calidad y Acreditación (ANECA).
La institución leonesa ha logrado la aprobación del 100% de las solicitudes presentadas por su personal docente e investigador funcionario.
Este logro sitúa a la ULE entre las cuatro únicas universidades españolas y la única de Castilla y León con una tasa de éxito total en esta exigente evaluación.
El vicerrector de Investigación y Transferencia, Santiago Gutiérrez, ha destacado que este resultado es un reflejo de la "calidad de la labor investigadora" y del trabajo "constante, riguroso y comprometido" de su comunidad universitaria.
Gutiérrez ha subrayado el compromiso de la Universidad de León por “fomentar un entorno académico que potencie la producción científica de calidad”.
El objetivo es que esta investigación tenga un “impacto en la sociedad, reforzando las políticas de apoyo a la investigación que se llevan desarrollando en los últimos años", ha afirmado el vicerrector.




